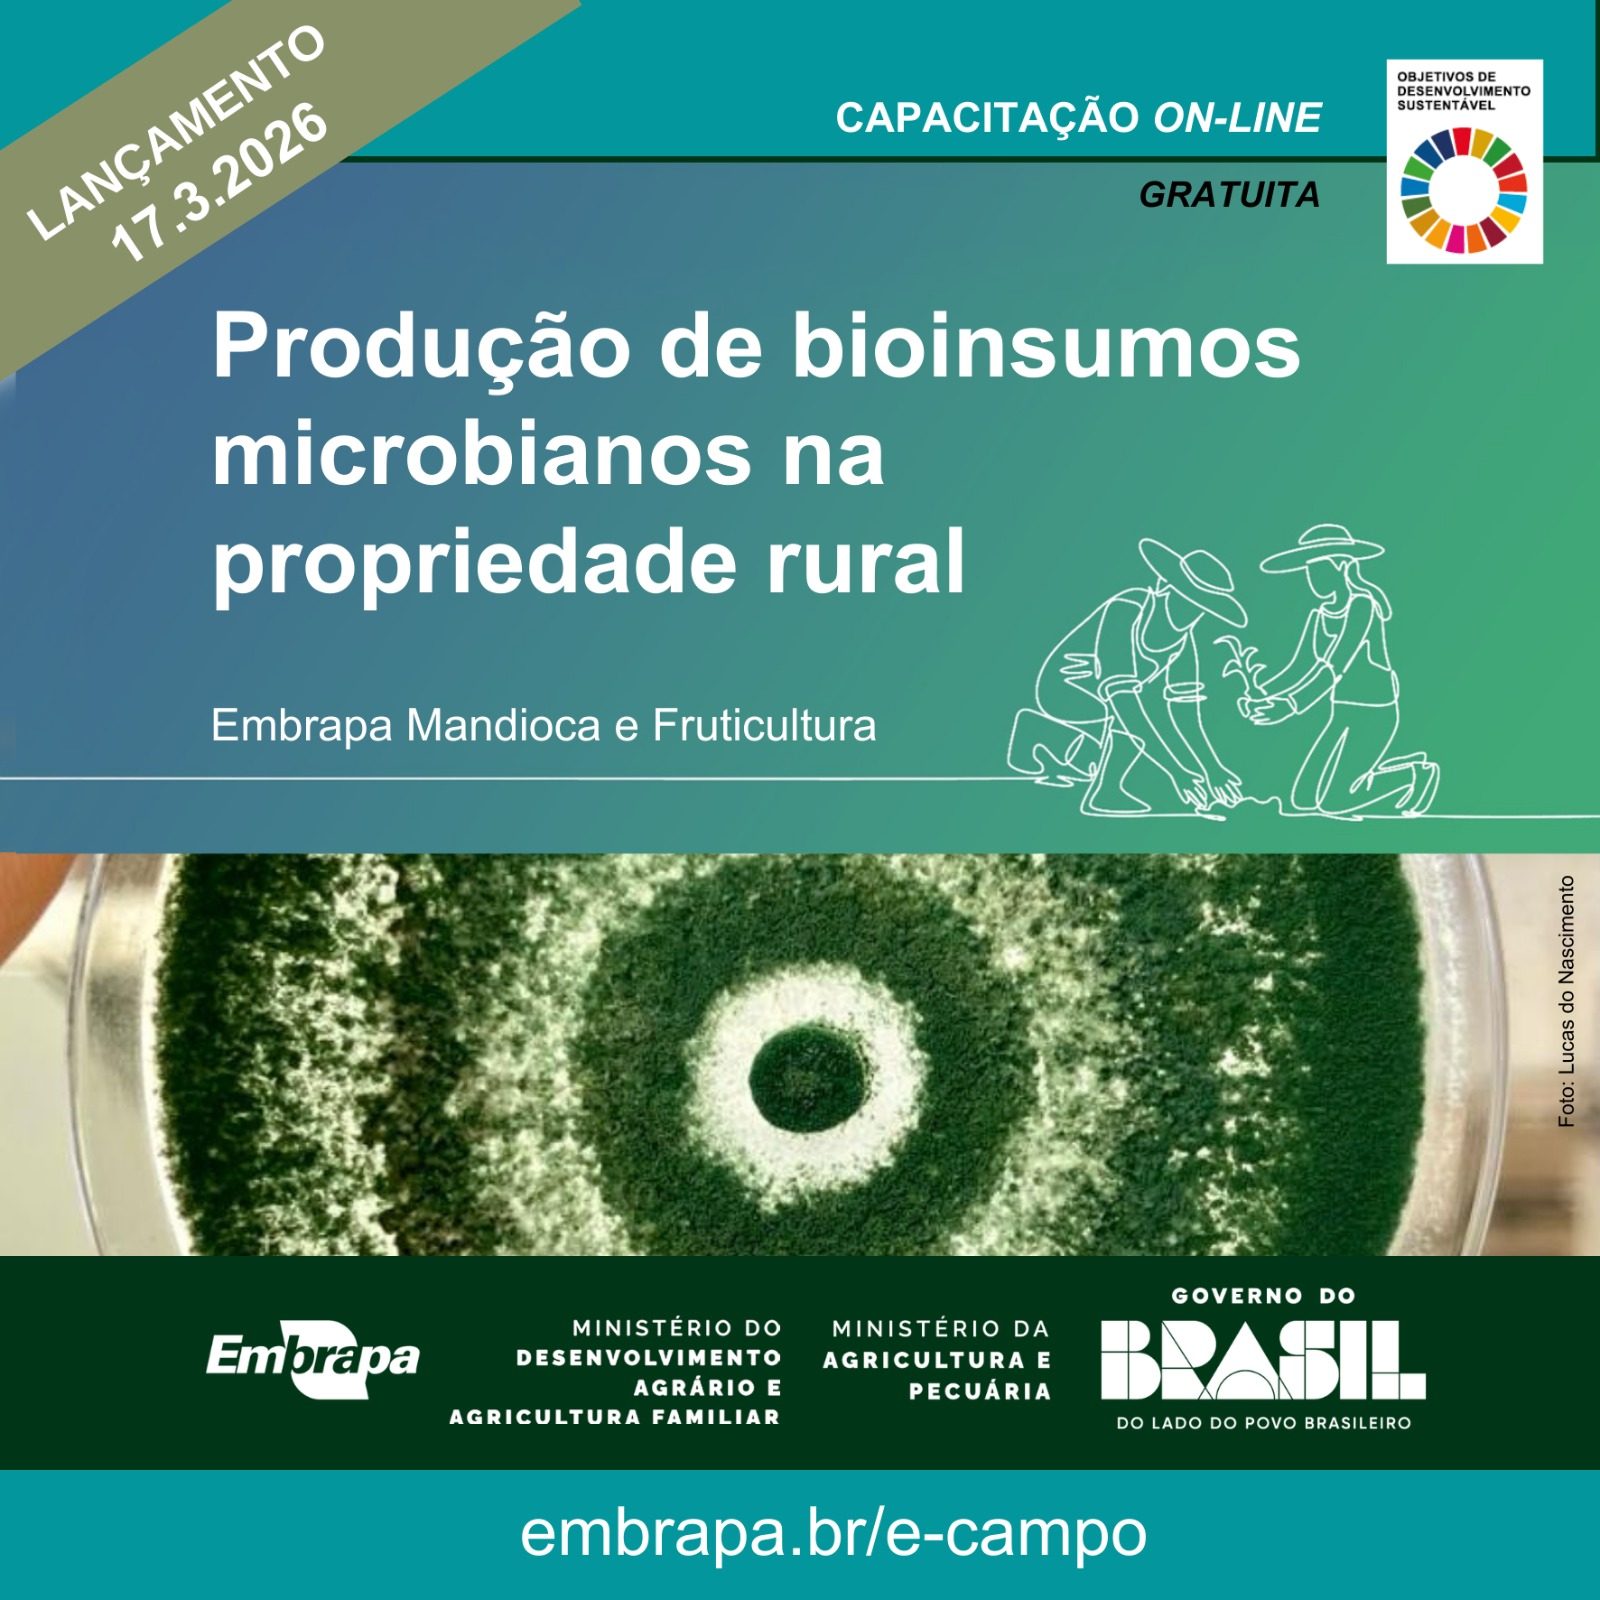

Aprenda a produzir bioinsumos on-farm com o novo curso gratuito da Embrapa. Domine a técnica, entenda a nova lei e garanta eficiência e segurança na sua propriedade.
Capacitar agricultores familiares, cooperativas rurais e agentes de assistência técnica e extensão rural a compreender e aplicar os fundamentos técnicos, práticos e legais necessários para produzir e utilizar bioinsumos microbianos de forma segura, eficiente e sustentável nas próprias propriedades é o objetivo do novo curso on-line gratuito da plataforma e-Campo, a vitrine de capacitações a distância da Embrapa.
O lançamento será na próxima terça (17) e integra a programação da Feira Nacional de Máquinas e Tecnologias para a Agricultura Familiar, realizada pela Embrapa em conjunto com o Ministério do Desenvolvimento Agrário e Agricultura Familiar (MDA), de 16 a 18 de março, em Campinas (SP).
Conforme a Lei 15.070/2024, bioinsumo é um produto, processo ou tecnologia de origem vegetal, animal ou microbiana, destinado ao uso na produção, armazenamento e beneficiamento de produtos agropecuários, nos sistemas de produção agrícolas, pecuários, aquícolas ou florestais, que interfira positivamente no crescimento, desenvolvimento e mecanismo de resposta de animais, plantas, microrganismos e substâncias derivadas.
No caso dessa capacitação, o foco é a produção na propriedade (on farm) de bioinsumos de microrganismos. Para a produção própria, faz-se necessária a adoção de padrões de qualidade e pureza no processo de multiplicação desses microrganismos, evitando assim a contaminação do ambiente e do homem e garantindo a efetividade do produto.
Desenvolvido pela Embrapa Mandioca e Fruticultura (BA) em parceria com o MDA, o curso “Produção de bioinsumos microbianos na propriedade rural” é realizado sem tutoria e assíncrono, permitindo ao participante acessar o conteúdo quando tiver disponibilidade. A capacitação foi estruturada em três módulos, totalizando 12 horas: Entendendo os microrganismos e sua multiplicação na propriedade; A nova lei de bioinsumos e o que ela muda na prática; e Segurança, benefícios e cuidados na produção dentro da propriedade para consumo próprio. Os módulos serão liberados por semana, o primeiro no lançamento e os demais nas semanas seguintes.
“Ao final do curso, esperamos que o participante seja capaz de identificar os conceitos básicos sobre microrganismos benéficos, suas funções no solo e nas plantas e os princípios técnicos para sua multiplicação e uso prático no sistema de produção rural; relacionar os principais pontos da legislação que orienta e regula a produção, o uso e a responsabilidade sobre bioinsumos produzidos na propriedade rural, além de reconhecer os principais benefícios do uso de bioinsumos na agricultura familiar e identificar os cuidados, proibições e boas práticas exigidas pela legislação para garantir uma produção segura, eficaz e dentro das normas legais“, pontua o pesquisador Harllen Alves, coordenador técnico do projeto.
VEJA MAIS:
- Ranking das cidades onde há mais buscas de terras rurais no Brasil – e o que ele revela sobre o agro
- Adoção de resolução das Nações Unidas que institui o Dia Internacional do Café
ℹ️ Conteúdo publicado pela estagiária Ana Gusmão sob a supervisão do editor-chefe Thiago Pereira
Quer ficar por dentro do agronegócio brasileiro e receber as principais notícias do setor em primeira mão? Para isso é só entrar em nosso grupo do WhatsApp (clique aqui) ou Telegram (clique aqui). Você também pode assinar nosso feed pelo Google Notícias
Não é permitida a cópia integral do conteúdo acima. A reprodução parcial é autorizada apenas na forma de citação e com link para o conteúdo na íntegra. Plágio é crime de acordo com a Lei 9610/98.